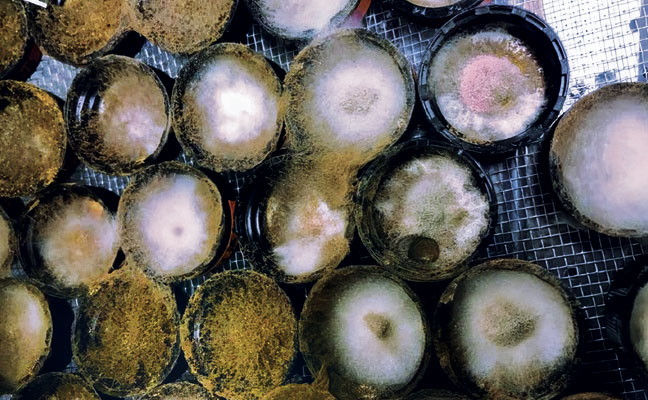
IMAGE: UNIVERSITY OF FLORIDA

It’s a common question in the truck: “This tube of gel bait has expired. Is it still good?” In an industry where “waste not, want not” often clashes with “follow the label,” pest management professionals (PMPs) are left wondering about the real-world shelf life of their products.
New research from the University of Kentucky puts this exact question to the test, examining the long-term palatability and efficacy of cockroach gel baits that were aged up to six months.
Key takeaways
- The study found the expired baits remained highly palatable to German cockroaches, which readily consumed them.
- All aging points lead to an 87% average mortality rate.
- The takeaway for PMPs is “waste not, want not” — expired baits are likely still effective and should be tested before being discarded.
The research: Testing aged baits
Researchers conducted “choice tests” using a lab-reared strain of German cockroaches (Blattella germanica). Two caps of bait were placed in each container, one with “rat chow” and one with cockroach gel bait.

The findings: Still Palatable, still effective
The results of the study were definitive and surprising, challenging common assumptions about expired products.
- Palatability: The cockroaches readily consumed the old baits. Some baits saw little to no decline in consumption, while others saw steeper declines. Despite changes in water content, all aging points resulted in a greater than 87% mortality rate.
Conclusion
The practical takeaway for PMPs is “waste not, want not.” While labels provide guidelines, this research shows the active ingredients in gel baits can remain stable and effective for far longer than expected. The matrix (the bait’s food component) also remained palatable for over a decade.
Before you’re so quick to throw that old tube away, this data suggests it’s likely just as effective as the day it was made.
Leave A Comment